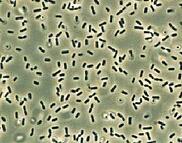
Glycocalyx capsule and slime layer

Back
BackFunctional Anatomy of Prokaryotic and Eukaryotic Cells: Microbiology Study Notes
Study Guide - Smart Notes

Functional Anatomy of Prokaryotic and Eukaryotic Cells
Overview: Comparing Prokaryotic and Eukaryotic Cells
This section introduces the fundamental differences between prokaryotic and eukaryotic cells, which are essential for understanding microbial structure and function.
Prokaryotes: Cells without a true nucleus; genetic material is not enclosed by a membrane.
Eukaryotes: Cells with a true nucleus; genetic material is enclosed within a nuclear membrane.
Key differences: Prokaryotes lack membrane-bound organelles and histones, while eukaryotes possess both. Cell division in prokaryotes occurs by binary fission, whereas eukaryotes divide by mitosis.
Cell Shapes and Arrangements in Prokaryotes
Bacteria exhibit a variety of shapes and arrangements, which are often used for classification and identification.
Common shapes:
Bacillus (rod-shaped)
Coccus (spherical-shaped)
Spiral (includes vibrio, spirillum, spirochete)
Other shapes: star-shaped, rectangular
Arrangements:
Pairs: diplococci, diplobacilli
Clusters: staphylococci
Chains: streptococci, streptobacilli
Groups of four: tetrads
Cubelike groups of eight: sarcinae
Scientific names often reflect shape: e.g., Bacillus (genus) is rod-shaped.




Structure of a Prokaryotic Cell
Prokaryotic cells have several key structures, both external and internal to the cell wall, that contribute to their function and pathogenicity.
External structures:
Glycocalyx: Viscous, gelatinous layer outside the cell wall; can be a capsule (organized, firmly attached) or slime layer (unorganized, loose). Contributes to virulence by preventing phagocytosis and aiding in biofilm formation.
Flagella: Filamentous appendages for motility; composed of filament, hook, and basal body. Enable movement via "runs" and "tumbles" and are used for chemotaxis.
Axial filaments: Found in spirochetes; allow corkscrew movement.
Fimbriae and Pili: Hairlike structures for attachment (fimbriae) and DNA transfer/motility (pili).
Internal structures:
Cell wall: Provides shape and protection; made of peptidoglycan in bacteria.
Plasma membrane: Selectively permeable phospholipid bilayer; site of ATP production and transport.
Cytoplasm: Contains DNA (nucleoid), ribosomes, and inclusions.
Nucleoid: Region containing the bacterial chromosome (circular DNA).
Ribosomes: Sites of protein synthesis (70S type in prokaryotes).
Inclusions: Reserve deposits of nutrients.
Endospores: Highly resistant, dormant structures formed under stress.

Bacterial Cell Wall: Composition and Types
The cell wall is a critical structure for bacterial survival, classification, and antibiotic targeting.
Peptidoglycan: Polymer of N-acetylglucosamine (NAG) and N-acetylmuramic acid (NAM) linked by polypeptides, forming a lattice.
Gram-positive cell walls: Thick peptidoglycan, teichoic acids, high susceptibility to penicillin, disrupted by lysozyme.
Gram-negative cell walls: Thin peptidoglycan, outer membrane with lipopolysaccharide (LPS), low susceptibility to penicillin, produce endotoxins.
Atypical cell walls: Acid-fast (waxy mycolic acid), mycoplasmas (no cell wall), archaea (pseudomurein or no wall).






Plasma (Cytoplasmic) Membrane: Structure and Function
The plasma membrane controls the movement of substances in and out of the cell and is essential for energy production and cellular integrity.
Structure: Phospholipid bilayer with embedded proteins (integral, peripheral), glycoproteins, and glycolipids.
Fluid mosaic model: Membrane components move freely; membrane is self-sealing.
Function: Selective permeability, ATP production, photosynthetic pigments (chromatophores).



Movement of Materials Across Membranes
Cells use passive and active processes to transport substances across membranes.
Passive processes:
Simple diffusion: Movement from high to low concentration.
Facilitated diffusion: Transport via membrane proteins; can be specific or nonspecific.
Osmosis: Movement of water across a selectively permeable membrane.
Osmotic pressure: Pressure needed to stop water movement.
Isotonic, hypotonic, hypertonic solutions: Affect water movement and cell integrity.
Active processes:
Active transport: Requires ATP and transporter proteins; moves substances against gradient.
Group translocation: Substance is chemically altered during transport.





Internal Structures: Cytoplasm, Nucleoid, Ribosomes, Inclusions, Endospores
Prokaryotic cells contain several internal structures vital for their survival and function.
Cytoplasm: Aqueous substance containing water, proteins, carbohydrates, lipids, ions, DNA, ribosomes, and inclusions.
Nucleoid: Contains the bacterial chromosome (circular DNA); plasmids may carry additional genes.
Ribosomes: 70S type; site of protein synthesis; target for certain antibiotics.
Inclusions: Reserve deposits (e.g., phosphate, polysaccharide, lipid, sulfur, gas vacuoles, magnetosomes).
Endospores: Dormant, highly resistant structures formed under stress; important in food safety and disease.

Eukaryotic Cell Structure
Overview of Eukaryotic Cell Structures
Eukaryotic cells are more complex than prokaryotic cells, containing numerous membrane-bound organelles.
Flagella and cilia: Projections for locomotion or moving substances; flagella are long and few, cilia are short and numerous. Both have a 9+2 microtubule arrangement and move in a wavelike manner.
Cell wall and glycocalyx: Cell walls found in plants, algae, fungi (cellulose, chitin, glucan, mannan); glycocalyx found in animal cells, strengthens surface and aids in cell recognition.
Plasma membrane: Similar to prokaryotes but contains sterols and carbohydrates; capable of endocytosis (phagocytosis, pinocytosis, receptor-mediated).
Cytoplasm: Contains cytosol, cytoskeleton (microfilaments, intermediate filaments, microtubules), and enables cytoplasmic streaming.
Ribosomes: 80S type (60S + 40S subunits) in cytoplasm and on ER; 70S type in mitochondria and chloroplasts.



Organelles of Eukaryotic Cells
Eukaryotic organelles perform specialized functions essential for cell survival and activity.
Nucleus: Double membrane (nuclear envelope) encloses DNA; DNA complexed with histones to form chromatin, which condenses into chromosomes during cell division.
Endoplasmic reticulum (ER):
Rough ER: Studded with ribosomes; site of protein synthesis.
Smooth ER: Synthesizes membranes, fats, hormones.
Golgi complex: Modifies and transports proteins from ER via secretory vesicles.
Lysosomes: Contain digestive enzymes; formed in Golgi complex.
Vacuoles: Storage and transport; formed by Golgi or endocytosis.
Mitochondria: Double membrane, inner folds (cristae), site of ATP production; contains 70S ribosomes and circular DNA.
Chloroplasts: Site of photosynthesis; contains thylakoids, chlorophyll, 70S ribosomes, circular DNA.
Peroxisomes: Oxidize fatty acids, destroy hydrogen peroxide.
Centrosomes: Organize mitotic spindle; critical for cell division.



Endosymbiotic Theory of Eukaryotic Evolution
The endosymbiotic theory explains the origin of eukaryotic cells from prokaryotic ancestors.
Larger bacterial cells engulfed smaller ones, leading to the development of organelles such as mitochondria and chloroplasts.
Evidence: Mitochondria and chloroplasts resemble bacteria in size and shape, have circular DNA, reproduce independently, possess 70S ribosomes, and have double membranes.
Summary Table: Gram-Positive vs. Gram-Negative Bacteria
Feature | Gram-Positive | Gram-Negative |
|---|---|---|
Peptidoglycan | Thick | Thin |
Teichoic acids | Present | Absent |
Outer membrane | Absent | Present |
Susceptibility to penicillin | High | Low |
Exotoxins | Produced | Produced |
Endotoxins | Absent | Present (Lipid A) |
Flagella basal body rings | 2 | 4 |
Key Terms
Prokaryote: Cell lacking a nucleus and membrane-bound organelles.
Eukaryote: Cell with a nucleus and membrane-bound organelles.
Peptidoglycan: Polymer forming bacterial cell wall.
Glycocalyx: External polysaccharide/polypeptide layer.
Flagella: Motility appendages.
Fimbriae/Pili: Attachment and DNA transfer structures.
Endospore: Dormant, resistant bacterial cell.
Osmosis: Water movement across membrane.
Endosymbiotic theory: Origin of eukaryotic organelles from prokaryotes.
Important Equations
Osmosis:
Facilitated Diffusion: where k is a constant, C is concentration
